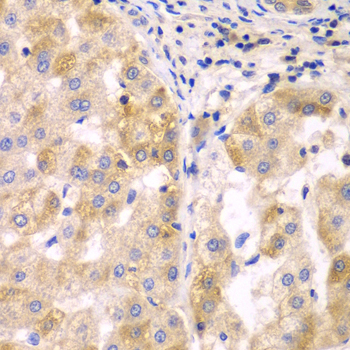

For quotations, please use our online quotation form, and you may also contact us by
service@kendallscientific.com
+1-888.733.6849 (Toll-free)
+1-617.299.7367 (Int’l))
+1-888.733.6849
Our customer service representatives are available 24 hours, Monday through Friday to assist you.| Reactivity | Human Mouse |
| Tested applications | WB IHC IF |
| Recommended Dilution | WB 1:500 - 1:2000 IHC 1:50 - 1:200 IF 1:50 - 1:100 |
| Calculated MW | 41kDa |
| Observed MW | Refer to figures |
| Immunogen | Recombinant protein of human SULT2B1 |
| Storage Buffer | Store at -20℃. Avoid freeze / thaw cycles. Buffer: PBS with 0.02% sodium azide, 50% glycerol, pH7.3. |
| Synonym | HSST2; |
Western blot analysis of extracts of various cells, using SULT2B1 antibody.

Immunohistochemistry of paraffin-embedded human liver cancer using SULT2B1 antibody at dilution of 1:100 (x40 lens).

Immunohistochemistry of paraffin-embedded human kidney cancer using SULT2B1 antibody at dilution of 1:100 (x40 lens).

Immunohistochemistry of paraffin-embedded mouse lung using SULT2B1 antibody at dilution of 1:100 (x40 lens).

Immunohistochemistry of paraffin-embedded mouse kidney using SULT2B1 antibody at dilution of 1:100 (x40 lens).

Immunofluorescence analysis of A549 cell using SULT2B1 antibody.

Immunofluorescence analysis of A549 cell using SULT2B1 antibody.
Sulfotransferase enzymes catalyze the sulfate conjugation of many hormones, neurotransmitters, drugs, and xenobiotic compounds. These cytosolic enzymes are different in their tissue distributions and substrate specificities. The gene structure (number and length of exons) is similar among family members. This gene sulfates dehydroepiandrosterone but not 4-nitrophenol, a typical substrate for the phenol and estrogen sulfotransferase subfamilies. Two alternatively spliced variants that encode different isoforms have been described.
N/A